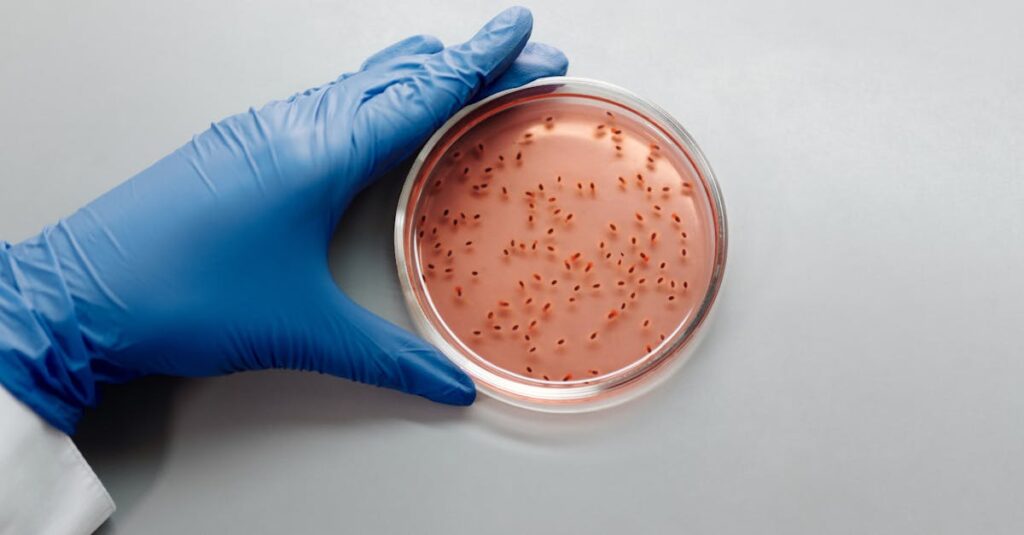
découvrez l'importance du microbiote intestinal et son rôle essentiel dans la santé digestive, le système immunitaire et le bien-être général.

La santé digestive est aujourd’hui au cœur des préoccupations. Notre ventre abrite un univers fascinant, peuplé d’une immense diversité de micro-organismes formant le microbiote intestinal. Ce dernier est une pièce maîtresse non seulement pour la digestion, mais aussi pour le maintien d’un équilibre intestinal indispensable à notre bien-être global. Il est désormais démontré que certains aliments, loin d’être de simples combustibles, interagissent directement avec cette flore, influençant notre immunité, notre humeur, et même la prévention de certaines maladies. Comprendre ces liens profonds est une démarche essentielle pour apprendre à nourrir cette communauté invisible qui travaille sans relâche pour nous protéger.
Depuis plusieurs années, la recherche scientifique fait un bond grâce aux méthodes modernes comme le séquençage génétique, permettant de décrypter la complexité de ce micro-univers. Un microbiote sain repose sur une grande diversité de bactéries et autres micro-organismes symbiotiques, touchés à la fois par nos choix alimentaires et notre mode de vie. Ainsi, savoir quels aliments privilégier pour soutenir cette flore précieuse tout en évitant ceux qui peuvent la déséquilibrer est devenu une priorité concrète et accessible. Ce lien entre nourriture et flore intestinale révèle une nouvelle façon d’aborder la nutrition : pas seulement en termes d’apport calorique ou de macro-nutriments, mais comme une danse subtile avec notre écosystème intérieur.
Cette dynamique a des retombées palpables dans notre quotidien : la digestion s’améliore, les inflammations intestinales diminuent, les sensations de ballonnements s’atténuent, et la récupération énergétique est facilitée. Pourtant, cette démarche ne se limite pas au domaine de la médecine. Elle s’invite naturellement dans nos cuisines et nos habitudes, offrant des solutions simples et concrètes à travers des aliments faciles à intégrer au quotidien. Il ne s’agit pas ici de suivre un régime rigide, mais d’échanger avec notre flore intestinale en privilégiant des ingrédients nourrissants, savoureux et accessibles à tous.
Dans cet esprit, nous verrons comment la composition de notre microbiote peut être façonnée par ce que nous mangeons, quels aliments peuvent agir comme de véritables alliés pour renforcer notre santé digestive, et comment adopter une approche équilibrée, réaliste et bienveillante envers nos intestins.
En bref :
- Le microbiote intestinal est un écosystème unique composé de milliers d’espèces microbiennes jouant un rôle clé dans la digestion, l’immunité et le métabolisme.
- Aliments probiotiques et prébiotiques participent activement à l’équilibre intestinal en nourrissant les bonnes bactéries et en favorisant la fermentation bénéfique.
- Une alimentation variée riche en fibres, légumes, céréales complètes et aliments fermentés soutient la diversité et la richesse du microbiote.
- La dysbiose, ou déséquilibre du microbiote, est liée à plusieurs pathologies digestives et métaboliques, mais aussi à des troubles inflammatoires et neurologiques.
- Des approches personnalisées émergent en médecine, mêlant probiotiques, transplantation fécale et modulations alimentaires pour restaurer la flore et apaiser l’inflammation.
Le microbiote intestinal, un univers fascinant au cœur de notre digestion
Ce que l’on appelle communément la flore intestinale désigne un ensemble très dense de micro-organismes, notamment des bactéries, virus, champignons et autres petites communautés vivant en équilibre dans notre tube digestif. À titre d’exemple, on estime qu’environ 10¹³ micro-organismes cohabitent dans notre intestin, une quantité équivalente au nombre de cellules de notre corps. Cette biodiversité est particulièrement concentrée dans le côlon, où des milliards de bactéries disposent d’un environnement sans oxygène et peu acide, idéal à leur développement. La composition du microbiote est à la fois propre à chaque individu et régulée par un socle commun d’espèces essentielles à la santé digestive.
Des avancées majeures dans l’étude du métagénome intestinal ont permis de révéler cette complexité. Plutôt que de cultiver les bactéries une à une, la technique du séquençage haut débit révèle la composition globale et les métabolites produits par le microbiote. Parmi ceux-ci, les productions issues de la fermentation des fibres alimentaires sont capitales : elles génèrent notamment des acides gras à chaîne courte qui nourrissent les cellules de la muqueuse intestinale et qui participent à réduire l’inflammation locale.
Le microbiote n’est pas un simple invité passif. Il joue un rôle actif pour améliorer la digestion des aliments notamment ceux que notre corps ne peut pas traiter seul, comme les fibres insolubles et certains polysaccharides. Il participe aussi à la synthèse de vitamines indispensables comme la vitamine K ou certaines vitamines B. L’interaction entre le microbiote et le système immunitaire détermine en grande partie l’intégrité de la barrière intestinale, qui empêche le passage de bactéries pathogènes dans le sang et réduit les réactions inflammatoires systémiques.
Par ailleurs, la qualité et la diversité du microbiote fluctuent selon plusieurs facteurs – l’âge, l’alimentation, l’exposition aux médicaments et l’environnement. Un microbiote déséquilibré, ou dysbiose, peut favoriser l’apparition de troubles digestifs, dont certains syndromes inflammatoires et allergies alimentaires. Il influence même plus largement notre santé, contribuant au développement de maladies métaboliques, cardiovasculaires et neurologiques. C’est pourquoi il est devenu crucial de veiller à cet écosystème avec une alimentation adaptée.

Les aliments probiotiques et prébiotiques : moteurs d’un équilibre intestinal durable
Notre alimentation est sans doute l’outil le plus accessible et efficace pour soutenir la santé de notre microbiote. Parmi les aliments à privilégier, il convient de distinguer deux grandes familles : les aliments probiotiques et les aliments prébiotiques.
Les probiotiques sont des micro-organismes vivants, principalement des bactéries bénéfiques, que l’on trouve naturellement dans certains aliments fermentés comme le pain au levain, le kéfir, la choucroute, le miso ou le yaourt nature. Ceux-ci sont capables de coloniser temporairement l’intestin et d’apporter un soutien direct à la flore en équilibrant les populations bactériennes. Par exemple, le yaourt nature, surtout lorsqu’il est sans sucres ajoutés ni additifs, est une source précieuse de probiotiques qui favorisent une bonne digestion et renforcent la barrière intestinale.
D’un autre côté, les prébiotiques désignent des fibres et autres substances non digestibles par l’homme mais fermentées par le microbiote, qui servent de « nourriture » aux bonnes bactéries. Des aliments riches en fibres solubles, comme la pomme, la banane, le fenouil ou les graines de chia, sont des exemples parfaits. Ces fibres permettent la fermentation par les bactéries, favorisant la production des acides gras à chaîne courte indispensables au bon fonctionnement de l’intestin. On retrouve aussi des fibres insolubles dans les céréales complètes et certains légumes verts qui augmentent le volume des selles et stimulent un transit régulier.
Un équilibre entre probiotiques et prébiotiques favorise une flore diverse, indispensable à une digestion harmonieuse. Néanmoins, il faut aussi être prudent dans leur consommation, car un excès peut engendrer des effets indésirables comme ballonnements ou inconforts digestifs. Par exemple, une cuillère à soupe quotidienne de graines de chia suffit souvent pour soutenir le transit sans excès.
Adopter une alimentation intégrant ces aliments réclame de la variété et du plaisir, deux ingrédients essentiels pour ne pas tomber dans un régime restrictif ou culpabilisant. Quel plaisir, par exemple, de préparer une salade fraîche avec un peu de fenouil croquant, accompagnée d’un yaourt nature agrémenté de fruits frais ! Ce genre de gestes simples mais éclairés contribue concrètement à une meilleure santé digestive.
L’impact des aliments fermentés et des fibres sur la santé digestive et l’immunité
La fermentation est un processus naturel ancestral qui a un double avantage : elle transforme les aliments en produits riches en probiotiques et elle augmente la biodisponibilité de certains nutriments. De la choucroute au kimchi en passant par le kombucha, ces aliments favorisent l’enrichissement du microbiote et améliorent la digestion.
Les fibres, quant à elles, constituent le carburant indispensable à la fermentation colique. Elles stimulent la production d’acides gras à chaîne courte, reconnus pour leurs propriétés anti-inflammatoires et leur rôle de barrière protectrice. Par exemple, la betterave, souvent méconnue, est une excellente source de fibres bénéfique à la fois pour nourrir la flore et pour faciliter un transit régulier. Sa préparation simplement rôtie avec un filet d’huile d’olive et des épices relève le goût tout en apportant un soutien digestif précieux.
Mais au-delà de simples effets digestifs, le microbiote, bien nourri par une alimentation adaptée, joue un rôle déterminant dans la modulation du système immunitaire intestinal. Une flore équilibrée participe à éviter des inflammations excessives, à distinguer les agents pathogènes des éléments neutres ou bénéfiques, et à réduire les risques d’allergies et d’intolérances.
En outre, certains aliments comme le saumon apportent des oméga-3, qui exercent une action anti-inflammatoire naturelle. Coupler des sources de ces acides gras à une alimentation riche en fibres et en aliments fermentés est une stratégie gagnante pour protéger sa santé digestive sur le long terme. Cette combinaison est d’autant plus recommandée pour les personnes souffrant de troubles inflammatoires chroniques du système digestif.

Microbiote et nutrition personnalisée : vers une approche durable de la santé intestinale
Les avancées médicales en 2026 ouvrent la voie à des traitements personnalisés qui prennent en compte la composition spécifique du microbiote de chaque individu. Cette individualisation est essentielle, car le microbiote est aussi unique que notre empreinte digitale, évoluant constamment en fonction de notre alimentation, notre style de vie et nos antécédents médicaux.
Par exemple, face aux déficits ou excès de certaines populations bactériennes, les interventions peuvent associer des probiotiques ciblés de nouvelle génération, sélectionnés pour leurs effets spécifiques, avec un apport adapté en prébiotiques. Un suivi régulier permet ainsi de restaurer un équilibre optimal et de réduire durablement les symptômes liés à une dysbiose.
En parallèle, des méthodes innovantes telles que la transplantation fécale progressent dans leur application, notamment pour les maladies inflammatoires chroniques de l’intestin. Cette technique consiste à réensemencer l’intestin d’un patient avec un microbiote sain provenant d’un donneur, ce qui peut conduire à une amélioration notable des symptômes. Bien que prometteuse, cette approche s’inscrit dans un cadre médical rigoureux et ne remplace pas l’adoption d’une alimentation adaptée.
Sur un plan plus pratique, intégrer des aliments naturels reconnus pour leurs effets bénéfiques sur le microbiote dans sa cuisine au quotidien est un excellent point de départ. Inviter les pommes récurrentes pour leur pectine régulatrice du transit, ou les graines de chia pour leur richesse en fibres et oméga-3, c’est construire une base solide pour une digestion fluide et une flore diversifiée.
Ce chemin vers une santé intestinale optimale conduit également à reconsidérer les aliments ultra-transformés souvent dépourvus de fibres ou chargés en additifs qui peuvent nuire au microbiote. Privilégier des ingrédients simples, cuisinés avec amour et selon les principes de la nutrition éclairée, c’est cultiver un équilibre durable et un bien-être réel, parfaitement en phase avec cet axe central entre alimentation et santé digestive.